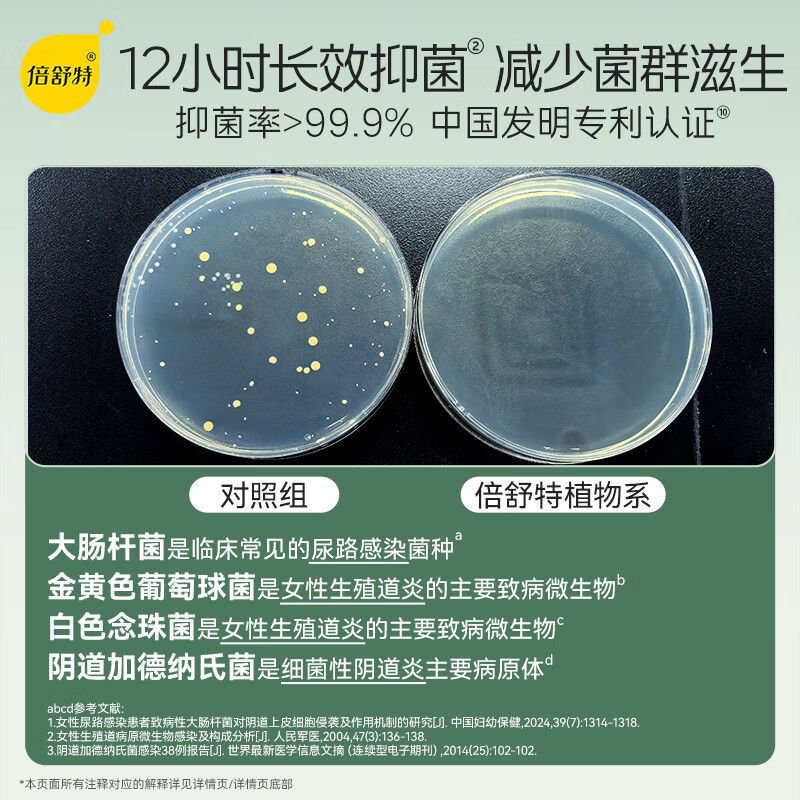

倍舒特植物系 全棉日夜用纯棉卫生巾
欢迎来到我们的产品介绍页面,今天为大家带来倍舒特植物系全棉日夜用纯棉卫生巾组合62片!这款卫生巾以其优质的材料和人体工学设计受到了广泛好评。无论是日常使用还是夜间休息,倍舒特都能为您提供持久而安心的保护。
产品亮点
- 纯棉材质:100%天然棉料制成,温和柔软,对皮肤友好。适合敏感肌体验舒适使用。
- 全日夜用设计:专为长时间持续性流动而设计的全面保护,让您无论白天还是黑夜都能放心安心。
- 人体工学切割:经过仔细研究和改良的设计,适应各种姿势与活动场合,确保舒适与稳固。
专属优惠
现在您可以以仅需 ¥87.12 的价格购买这款高品质卫生巾组合!通过使用我们的优惠链接,您还能享受更多促销活动。
用户反馈
- 总评价数:50,000条评论
- 好评率:高达99%的用户给出了积极的反馈,许多用户表示倍舒特卫生巾在使用中超乎预期。
产品图片

购买链接与促销信息
倍舒特植物系全棉日夜用纯棉卫生巾组合62片,不仅价格实惠,还提供满69元减8.8元优惠券的购买机会。无需犹豫,点击 产品详情 立即购买,享受高品质却低价的生活方式!
特别说明
- 自营品牌:保障正规渠道及产品真实性。
- 7天无理由退货:购买后七天内,如有任何问题均可享受无理由退货服务。
感谢您对我们的支持和信任。选择倍舒特,为自己更好的保健生活方式!
Share this content:


